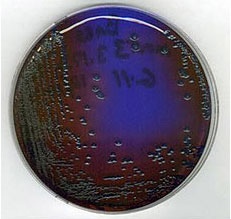
صورة لصفيحة بكتيريا من السالومونيكيدا الحمراء والخضراء

تم نشر هذا التحديث في فبراير 2016
أوضح صيف 2015 القدرة الملحوظة لأعداد سمك القاروس الصغير على الانتعاش بعد حادثة نفوق الأسماك. وقد ساهم الانتعاش، وإن لم يكن بشكل كامل، في نجاح سنة التفريخ في 2010. وقد وقعت آخر حادثة نفوق في ربيع عام 2014 عندما أبلغ بعض الصيادين والمواطنين المهتمين عن أعداد صغيرة من أسماك القاروس الصغيرة النافقة والمريضة في نهر شيناندواه. تحققت DWR من وجود نسبة عالية نسبيًا (30% ) من أسماك القاروس الصغير وسمك الشمس الأحمر الصدر مع آفات وتشوهات أخرى في نهر ساوث فورك شيناندواه من بورت ريبابليك إلى فرونت رويال. أخذت DWR أيضًا عينات من جميع أنحاء نهر نورث فورك شيناندواه ولاحظت وجود نفس التشوهات في الأسماك، ولكن النسبة المئوية كانت أقل قليلًا.
على الرغم من أن مستجمع مياه نهر جيمس شهد أحداث وفيات مماثلة في الماضي، إلا أنه يبدو أن الأمور كانت هادئة إلى حد ما في الآونة الأخيرة. كانت تقارير الصيادين عن الأسماك النافقة أو المريضة في كاوباستشر وجاكسون وأعلى نهر جيمس شبه معدومة على مدار السنوات الأربع الماضية.
كانت التأثيرات الناجمة عن أحداث الوفيات/الأمراض 2014 في مستجمعات مياه نهر شيناندواه ثقيلة إلى حد ما في ذلك الربيع والصيف. ومع ذلك، قامت DWR بأخذ عينات من مجتمع الأسماك في خريف 2014 ووجدت وفرة من سمك القاروس الصغير 9 إلى 11 بوصة والكثير من أسماك القاروس الصغيرة جدًا أيضًا. واستناداً إلى آخر عينة خريفية 2015 ، فإن مجموعة 9 إلى 11 بوصة من أسماك الفصيلة الصغيرة 11 إلى 13 بوصة خلال صيف 2015 ، وباستثناء أي تفشي للأمراض في 2016 من المتوقع أن تصل الأسماك إلى النطاق 13 إلى 15 بوصة بحلول شهر أغسطس 2016. بالإضافة إلى ذلك، سيجلب عام التفريخ الناجح في 2012 مجموعة أخرى من سمك القاروس الصغير 9 إلى 11 بوصة للصيادين للاستمتاع بها في 2016. أيام أفضل قادمة لصيادي سمك القاروس في حوض نهر شيناندواه.
من الشائع أن تظهر بعض أنواع التشوهات على عدد قليل من الأسماك في مجموعة الأسماك مثل الآفات أو البقع الداكنة من الجلد أو النتوءات البارزة أو فقدان القشور أو الزعانف المنقسمة/المتآكلة أو الخياشيم المتغيرة اللون/المتآكلة (انظر الصور في أسفل هذه الصفحة). ومن الناحية التاريخية في مستجمعات مياه نهر شيناندواه عندما 20% أو أكثر من الأسماك في مجموعة ما تظهر عليها حالة شذوذ واحدة أو أكثر من هذا النوع، يصبح الأمر أكثر إثارة للقلق. حدثت حالات مزمنة لنفوق الأسماك المزمنة في فصل الربيع وأحداث مرضية في نهر شيناندواه على مدى العقد الماضي، وكانت موجودة في أعالي نهر جيمس من 2007-2010. لم تكن هذه النوبات موحدة في الموقع أو الشدة. كان سمك القاروص الصغير البالغ، وسمك الشمس الأحمر الصدر، وسمك القاروص الصخري هي الأسماك الرئيسية المتضررة. ومع ذلك، تم إلحاق العديد من الأنواع الأخرى أيضًا. وعادةً ما تظهر على الأسماك المصابة تقرحات مفتوحة أو "آفات" على جوانب أجسامها، وبعض الأسماك النافقة والنافقة لا تظهر عليها أي تشوهات خارجية واضحة.
وقد ثبت أن تحديد سبب هذه الوفيات/الأمراض صعب للغاية. وقد أجرى العلماء ولا يزالون يجرون دراسات متعمقة حول صحة الأسماك ومسببات الأمراض وجودة المياه والتعرض للملوثات والسموم التي تطلقها البكتيريا (الطحالب الخضراء المزرقة). وتركز الدراسات الحالية على معطلات الغدد الصماء والسموم البكتيرية (الطحالب الخضراء المزرقة) وتأثيرات جودة المياه. إن حقيقة وقوع هذه الأحداث في مستجمعات مياه متعددة تختلف في نواحٍ عديدة قد زاد من تعقيد فهم السبب الرئيسي.
شملت الفحوصات الصحية للأسماك حتى الآن: علم أمراض الأنسجة (الشكل 2)، وعلم الطفيليات، وعلم الجراثيم، وعلم الفيروسات، وتحليل الدم والكبد (الشكل 3). وقد تم جمع هذه المعلومات من الأنهار المتأثرة، وكذلك من عدد قليل من الأنهار "المرجعية" التي لم تحدث فيها حالات النفوق/المرض هذه. وقد تم تحليل عينات صحة الأسماك من قبل العديد من الجامعات، ومختبر صحة الأسماك في شمال شرق الولايات المتحدة الأمريكية التابع لهيئة الأسماك والحياة البرية الأمريكية، ومختبر صحة الأسماك الشرقية التابع للجمعية الجيولوجية الأمريكية. وفي حين جمع الباحثون عددًا كبيرًا من البيانات المتعلقة بصحة الأسماك، إلا أن ربط نوبات المرض والنفوق بسبب واحد كان بعيد المنال. تم وصف نتائج البحث التفصيلية في التقرير النهائي لجامعة فيرجينيا للتكنولوجيا "التحقيق في وفيات سمولماوث باس في أنهار فيرجينيا" (Orth et al. 2009) (PDF).

ومن خلال البحث والرصد الذي تم إجراؤه حتى الآن، لم يكن هناك أي دليل قاطع على أن متغيرات جودة المياه أو الملوثات الكيميائية هي المسؤولة المباشرة عن هذه الأحداث المتعلقة بنفوق/مرض الأسماك (الشكل 4). تم قياس مستويات الملوثات في الأنهار المتأثرة بالإضافة إلى عدد قليل من الأنهار التي لا تحدث فيها حالات نفوق/مرض الأسماك هذه. تم قياس مستويات الملوثات في كل من التدفق الأساسي وأثناء أحداث الجريان السطحي (الشكل 5). ومع ذلك، تجدر الإشارة إلى أنه لم يتم قياس كل مركب كيميائي ممكن، وأن التركيزات السامة للأسماك للعديد من المركبات الكيميائية غير معروفة. كما أنه ليس من المفهوم جيدًا كيف يمكن لبعض المركبات الكيميائية أن "تتفاعل" مع بعضها البعض وتصبح سامة للأسماك. هناك حاجة إلى إجراء المزيد من الأبحاث في هذا المجال لتحديد ما إذا كانت هناك عوامل إجهاد متعددة قد تحدث في نفس الوقت للتأثير على صحة هذه الأسماك. يمكن الحصول على النتائج التفصيلية من مشاريع مراقبة جودة المياه والملوثات من مكتب منطقة الوادي التابع لوزارة جودة البيئة في فرجينيا.
ثبت أن بعض المركبات الكيميائية والمعادن الثقيلة تثبط الجهاز المناعي وتؤثر على نمو بعض الكائنات المائية. يُشار إلى هذه الملوثات باسم "معطلات الغدد الصماء". كما تندرج الأشكال الطبيعية والاصطناعية لهرمون الإستروجين ضمن هذه الفئة. تم قياس النشاط الإستروجيني في عينات المياه المأخوذة في جميع أنحاء نهر شيناندواه وروافده بمستويات قد تسبب تأثيرات بيولوجية في الأسماك. على الرغم من أنها على الأرجح ليست صحية، إلا أنه لا يوجد دليل قاطع أو قاطع على أن هذه المواد الكيميائية تؤثر سلبًا على الجهاز المناعي للأسماك في نهر شيناندواه وتساهم في حالات النفوق/الأمراض. لا يزال الباحثون في هيئة المسح الجيولوجي الأمريكية يشاركون بنشاط في فهم كيفية تأثير بعض الملوثات على الجهاز المناعي للأسماك. يشمل هذا البحث أسماكًا مأخوذة من أنهار فيرجينيا بالإضافة إلى أنهار أخرى في مستجمعات مياه خليج تشيسابيك. تواصل DWR العمل مع هؤلاء العلماء من خلال توفير عينات من الأسماك.
خلال ربيع عام 2015 بدأت DWR بجمع كبد سمك القاروس الصغير في جميع أنحاء نهر ساوث فورك شيناندواه لاختبار وجود الميكروسيستين. يوجد المايكروسيستين في البيئة المائية عند وجود الطحالب الخضراء المزرقة (البكتيريا الزرقاء). ثبت أن سموم الطحالب الخضراء المزرقة قاتلة للأسماك والبشر والماشية والحيوانات الأليفة. تزدهر معظم الطحالب الخضراء المزرقة في الأنظمة المائية التي تحتوي على نسبة عالية من الفوسفور إلى النيتروجين وتدفق ودرجة حرارة مناسبة. بالنظر إلى العوامل البيئية المواتية قد تحل الطحالب الخضراء المزرقة محل الطحالب غير السامة. عندما ترتفع درجات حرارة المياه تبدأ بعض الطحالب الخضراء المزرقة بالموت. يتسبب ذلك في انفجار جدار خلية الطحالب وإطلاق السموم في عمود الماء. مرة أخرى، ربما لا يكون هذا هو السبب الجذري لنفوق الأسماك. ومع ذلك، إلى جانب عوامل ضغط أخرى قد يكون أحد العوامل الرئيسية التي تساهم في هذه الأحداث. وفي 2015 كانت مستويات الميكروسيستين في كبد سمك القاروس الصغير منخفضة نسبياً. كما كان هناك أيضًا عدد قليل جدًا من الأسماك المصابة بآفات وتقارير قليلة جدًا عن حالات نفوق الأسماك. تخطط شركة DWR لجمع عينات كل ربيع حتى حدوث حدث نفوق آخر للأسماك لتحديد ما إذا كان هناك ارتفاع في مستويات الميكروسيستين في كبد سمك القاروس الصغير.
- الشكل 2. جمع عينات التشريح النسيجي من سمك القاروس الصغير.
- الشكل 3. أخذ عينة دم من سمك القاروس الصغير البالغ الحي.
In the past DWR and USGS focused on a particular biological pathogen as a possible cause of the disease/mortality episodes. Smallmouth bass, redbreast sunfish and rock bass were collected before, during and after the April/May mortality period from different rivers and analyzed for the presence of pathogenic bacteria from 2008 to 2012. The pathogenic bacterium Aeromonas salmonicida was present and typically the most abundant on fish sampled during the fish kill period. This bacterium was not present on fish in the Maury River during the fish kill period and there have not been any fish kill issues or reports in the Maury River of this type. A. salmonicida was not present on fish before or after the fish kill period. Although this bacterium is present and has the ability to greatly impact fish health we are not aware of why it may be impacting the fish population. A. salmonicida is present in multiple aquatic systems around the world. The simple presence usually doesn’t cause such impacts on bass and sunfish populations. It most commonly causes disease in trout and salmon. Environmental factors such as temperature, flow and eutrophication may also play a role in its ability to flourish. The bacteria is considered a “cold-water” fish pathogen since it cannot survive water temperatures > 74° F. USGS researchers have identified that coldwater tributaries entering the river and large springs upwelling in the river are “reservoirs” of this bacteria where it can survive year-round. A. salmonicida is a very virulent bacterium that may influence populations with only its presence. However, if any additional environmental, behavioral or chemical stress is added to the population while A. salmonicida is present in the river then it would have a higher probability of having a detrimental impact on the population. Although it seems A. salmonicida may be a major contributor to the mortality/disease events we now ask, why has it only impacted the fishery during the last decade and what may be stressing the population to let A. salmonicida thrive?
وفي حين خلص العلماء إلى أنهم قد لا يتمكنون أبدًا من تحديد مصدر هذه البكتيريا على وجه التحديد ولا متى تم إدخالها إلى هذه الأنهار، فإن معرفة المزيد عن هذا العامل الممرض قد يؤدي إلى فهم السبب الجذري للمشكلة. تشمل الأسئلة الإضافية التي يأمل الباحثون في الإجابة عنها فيما يتعلق بهذه البكتيريا ما يلي:
- هل تصبح الأسماك أكثر مقاومة للبكتيريا بمرور الوقت؟
- هل تؤثر بعض العوامل البيئية على فوعة البكتيريا؟
- هل هناك عوامل إجهاد أخرى مثل سموم الطحالب الخضراء المزرقة أو مسببات اختلال الغدد الصماء التي تؤثر على الجهاز المناعي للأسماك مما يسمح لسمك السلمونيسيدا بالتأثير على تعدادها؟
- الشكل 4. أخذ عينة مياه للتحليل.
- الشكل 5. وضع جهاز أخذ العينات الكيميائية السلبية في النهر.
نظر الباحثون أيضًا إلى الحشرات المائية كطريقة محتملة لفهم سبب المشكلة في مستجمعات مياه نهر شيناندواه. تم التعاقد مع قسم علم الحشرات في جامعة فيرجينيا للتكنولوجيا من قبل وزارة الموارد المائية في 2006 لإجراء تقييم شامل لللافقاريات المائية في مستجمعات المياه في نهر شيناندواه. لسوء الحظ، لم تكشف الدراسة عن سبب نفوق الأسماك ومشاكل الأمراض. ومع ذلك، كانت النتيجة الرئيسية هي أن مجتمع الحشرات المائية في نهر شيناندواه يدل على مستجمعات المياه القائمة على الزراعة، وهو أكثر حيوية من نهر نيو ريفر في فيرجينيا ونهر سوسكويهانا في بنسلفانيا، وأكثر تنوعًا وصحة مما كان عليه في 1960. (تقرير دراسة اللافقاريات الكبيرة في شيناندواه (PDF))
- الشكل 6. مسح السمك بحثاً عن البكتيريا.
- الشكل 7. مزرعة أيروموناس سالمونيسيدا.
صور إضافية
- آفة بكتيرية على سمكة الشمس الحمراء الصدر.
- سمك القاروس الصغير الفموي مع مخاط زائد وتغير في لون الجلد الصبغي.
- سمك القاروس الصغير ذو الخياشيم المتغيرة اللون.
- سمك القاروس الصغير الفموي مع آفة.
- سمك القاروس الصغير المريض في المياه الضحلة.
- سمك القاروس الصغير مع آفة وفطريات.
- سمك القاروس الصغير الفموي مع آفة.
- سمك القاروس الصغير الفموي مع آفة.
- سمك القاروس الصغير مع آفة ملتئمة في أواخر الصيف (بالقرب من ذيل السمكة).
- سمكة الشمس الحمراء الصدرية ذات الآفة الدائرية (في المراحل المبكرة).